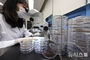
「蚊に気を付けてください」　韓国各地にマラリア注意報

記事入力 : 2025/06/25 17:53
「蚊に気を付けてください」 韓国各地にマラリア注意報
【NEWSIS】韓国各地にマラリア注意報が発令される中、25日午前に仁川市中区の仁川保健環境研究院媒介体感染病課実験室で、研究士たちが蚊の種類の分類作業を行っている様子。
疾病管理庁は、梅雨前後から次第にマラリア媒介蚊が増えると予想されるため、マラリア危険地域では媒介蚊の防除を強化し、蚊に刺されないための予防守則を順守するように注意を促した。
NEWSIS/朝鮮日報日本語版
<記事、写真、画像の無断転載を禁じます。 Copyright (c) Chosunonline.com>
関連ニュース